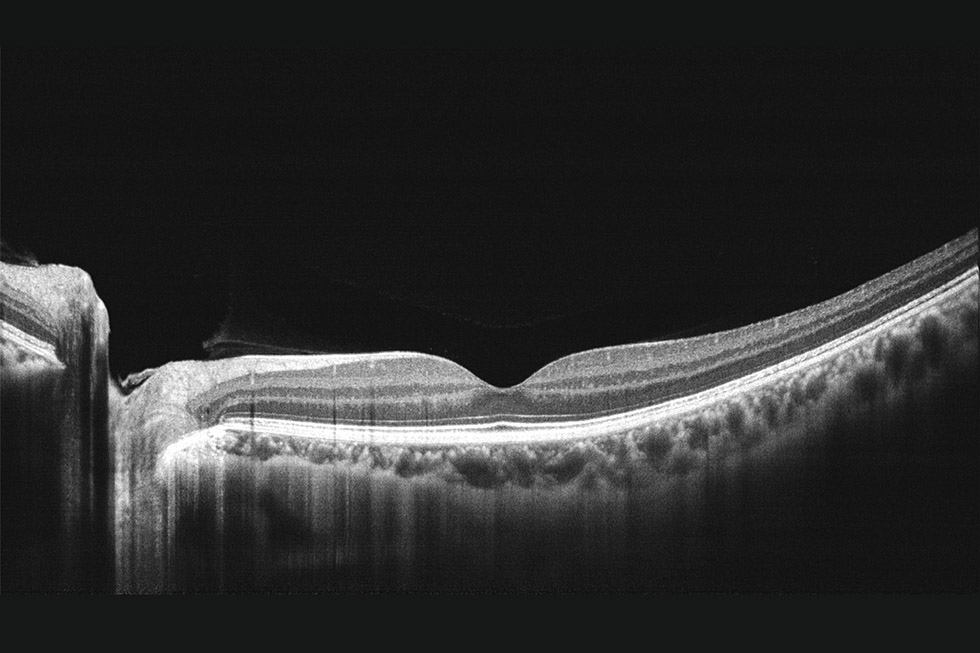
alt

- Opis produktu
Opis produktu:
- Technologia: Spektralne OCT (SOCT)
- Szybkość skanowania: do 130000 skanów na sekundę
- Źródło światła: Dioda superluminescencyjna (SLED) o długości fali 840nm
- Rozdzielczość osiowa: 5µm (optyczna), 2,7µm (cyfrowa)
- Rozdzielczość poprzeczna: 15µm (optyczna), 3µm (cyfrowa)
- Głębokość skanowania: 7,36mm (przedni odcinek) 3,1mm (tylny odcinek)
- Zakres regulacji refrakcji: od -20 do + 20D
- Opcjonalny moduł angio
PRZEDNI ODCINEK OKA
- Wizualizacja całej komory przedniej (16 x 7,63mm)
- W trybie standardowym aparat obrazuje od powierzchni przedniej rogówko do przedniej powierzchni soczewki. Oprogramowanie automatycznie oblicza głębokość komory przedniej (ACD – Anterior Chamber Depth), średnicę źrenicy, centralną grubość rogówki, kąty przesączania (AOD 500, TISA 500, AOD 750 i TISA 750), ATA (Anlge To Angle)
Tryb standardowy

Tryb soczewki
W trybie soczewki system obrazuje od przedniej do tylnej powierzchni soczewki i automatycznie oblicza jej grubość

VASCAN - ANGIO OCT (OPCJA)
Powierzchnia skanu
Obraz siatkówki 3x3, 6x6, 8x8 lub 12x8mm, nerwu wzrokowego 4,5x4,5 lub 6x6mm

Analiza zaawansowana
VASCAN oferuje pomiar unaczynienia poprzez pomiar gęstości naczyń, mapę Skeleton oraz pomiar przepływu
FAZ - analiza dołkowej strefy beznaczyniowej (FAZ – Foveal Avascular Zone) - powierzchnia, obwód, kolistość oraz FD 300 (gęstość naczyń w pierścieniu o szerokości 300 μm otaczającym strefę FAZ)

Mapa gęstości naczyń w oparciu o mapę Skeleton i gęstość perfuzji

Pomiar przepływu

OCT
SLO

OBRAZOWANIE 16mm

INTERFEJS

Pozostałe produkty z kategorii
Newsletter









